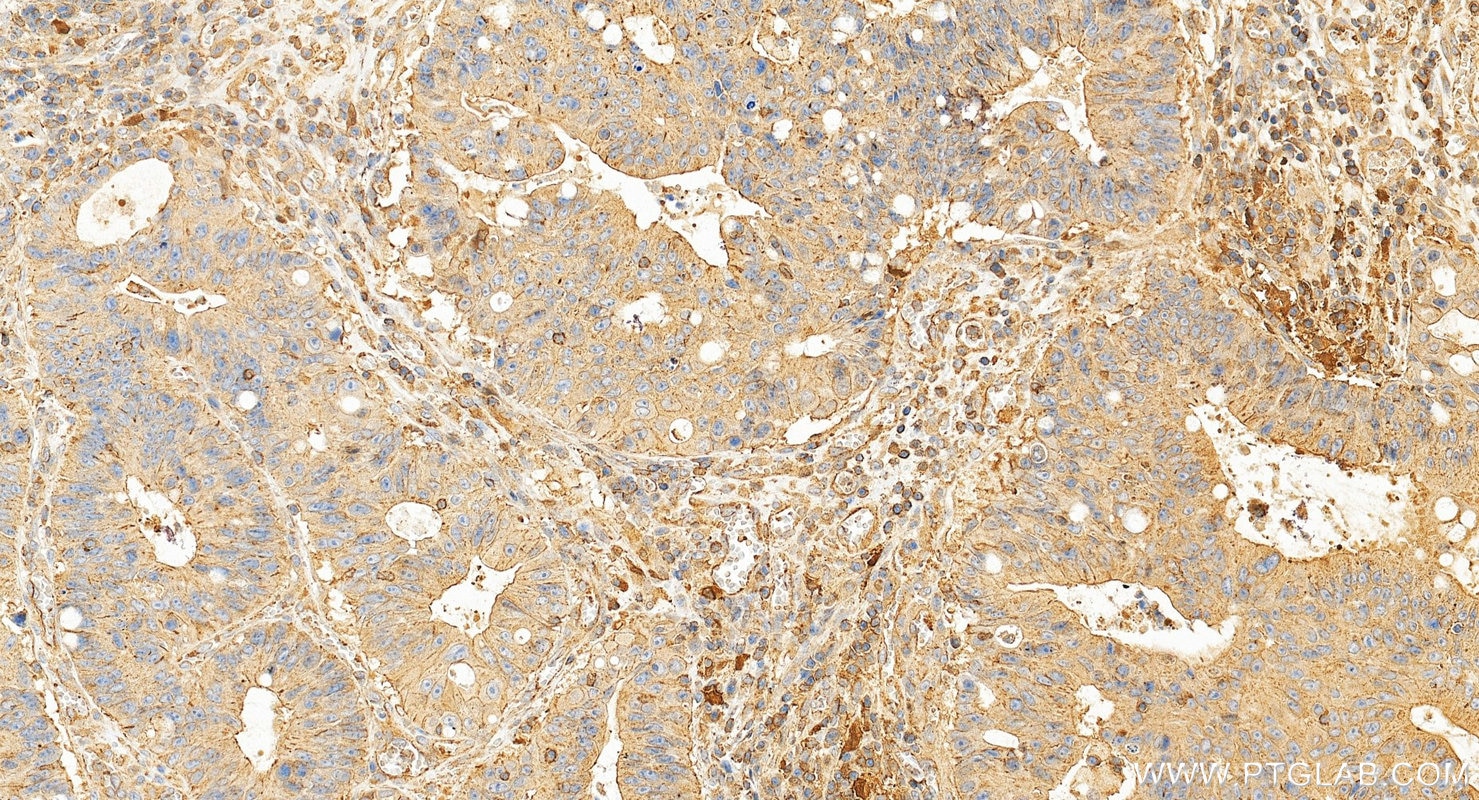
Immunohistochemistry (IHC) staining of human colon cancer tissue using IDO1 Monoclonal antibody (66528-1-Ig)
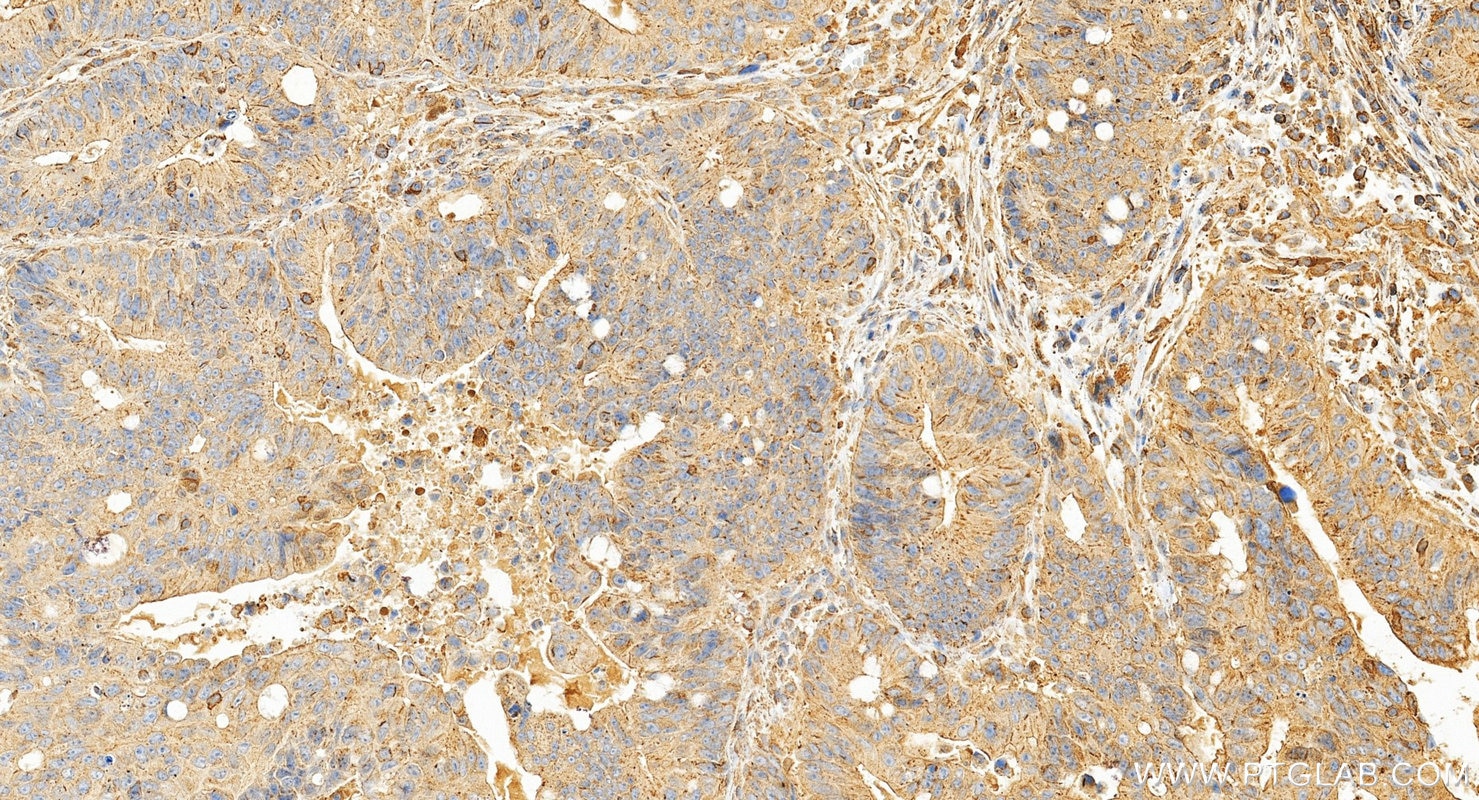
Immunohistochemistry (IHC) staining of human colon cancer tissue using IDO1 Monoclonal antibody (66528-1-Ig)

Tested Applications
| Positive WB detected in | HeLa cells, HSC-T6 cells, 4T1 cells, IFN gamma treated HeLa cells |
| Positive IHC detected in | human tonsillitis tissue, human colon cancer tissue Note: suggested antigen retrieval with TE buffer pH 9.0; (*) Alternatively, antigen retrieval may be performed with citrate buffer pH 6.0 |
| Positive IF/ICC detected in | SKOV-3 cells |
Recommended dilution
| Application | Dilution |
|---|---|
| Western Blot (WB) | WB : 1:5000-1:50000 |
| Immunohistochemistry (IHC) | IHC : 1:400-1:2000 |
| Immunofluorescence (IF)/ICC | IF/ICC : 1:400-1:2000 |
| It is recommended that this reagent should be titrated in each testing system to obtain optimal results. | |
| Sample-dependent, Check data in validation data gallery. | |
Published Applications
| WB | See 25 publications below |
| IHC | See 4 publications below |
| IF | See 6 publications below |
Product Information
66528-1-Ig targets IDO1 in WB, IHC, IF/ICC, ELISA applications and shows reactivity with human, mouse, rat samples.
| Tested Reactivity | human, mouse, rat |
| Cited Reactivity | human, mouse, rat |
| Host / Isotype | Mouse / IgG1 |
| Class | Monoclonal |
| Type | Antibody |
| Immunogen |
CatNo: Ag3953 Product name: Recombinant human IDO1 protein Source: e coli.-derived, PGEX-4T Tag: GST Domain: 1-403 aa of BC027882 Sequence: MAHAMENSWTISKEYHIDEEVGFALPNPQENLPDFYNDWMFIAKHLPDLIESGQLRERVEKLNMLSIDHLTDHKSQRLARLVLGCITMAYVWGKGHGDVRKVLPRNIAVPYCQLSKKLELPPILVYADCVLANWKKKDPNKPLTYENMDVLFSFRDGDCSKGFFLVSLLVEIAAASAIKVIPTVFKAMQMQERDTLLKALLEIASCLEKALQVFHQIHDHVNPKAFFSVLRIYLSGWKGNPQLSDGLVYEGFWEDPKEFAGGSAGQSSVFQCFDVLLGIQQTAGGGHAAQFLQDMRRYMPPAHRNFLCSLESNPSVREFVLSKGDAGLREAYDACVKALVSLRSYHLQIVTKYILIPASQQPKENKTSEDPSKLEAKGTGGTDLMNFLKTVRSTTEKSLLKEG Predict reactive species |
| Full Name | indoleamine 2,3-dioxygenase 1 |
| Calculated Molecular Weight | 403 aa, 45 kDa |
| Observed Molecular Weight | 42 kDa |
| GenBank Accession Number | BC027882 |
| Gene Symbol | IDO1 |
| Gene ID (NCBI) | 3620 |
| RRID | AB_2881891 |
| Conjugate | Unconjugated |
| Form | Liquid |
| Purification Method | Protein G purification |
| UNIPROT ID | P14902 |
| Storage Buffer | PBS with 0.02% sodium azide and 50% glycerol, pH 7.3. |
| Storage Conditions | Store at -20°C. Stable for one year after shipment. Aliquoting is unnecessary for -20oC storage. 20ul sizes contain 0.1% BSA. |
Background Information
IDO1 is the target for therapy in a range of clinical settings, including cancer, chronic infections, autoimmune and allergic syndromes, and transplantation. Elevated IDO1 expression is a hallmark of major viral infections including HIV, HBV, HCV or influenza and also of major bacteria infections, such as Tb, CAP, listeriosis and sepsis. Pathogens are able to highjack the immunosuppressive effects of IDO1 and make use of them to facilitate their own life cycle. MW of IDO1 is 40-42kd (PMID: 14502282; 17055065).
Protocols
| Product Specific Protocols | |
|---|---|
| IF protocol for IDO1 antibody 66528-1-Ig | Download protocol |
| IHC protocol for IDO1 antibody 66528-1-Ig | Download protocol |
| WB protocol for IDO1 antibody 66528-1-Ig | Download protocol |
| Standard Protocols | |
|---|---|
| Click here to view our Standard Protocols |
Publications
| Species | Application | Title |
|---|---|---|
J Gastroenterol Indoleamine 2,3-dioxygenase 1-mediated iron metabolism in macrophages contributes to lipid deposition in nonalcoholic steatohepatitis | ||
Pharmacol Res IDO1 can impair NK cells function against non-small cell lung cancer by downregulation of NKG2D Ligand via ADAM10. | ||
ACS Chem Neurosci 1-Methyl-4-phenyl-1,2,3,6-tetrahydropyridine Induced Parkinson's Disease in Mouse: Potential Association between Neurotransmitter Disturbance and Gut Microbiota Dysbiosis. | ||
Biochem Pharmacol IDO1-mediated AhR activation up-regulates pentose phosphate pathway via NRF2 to inhibit ferroptosis in lung cancer | ||
Chin J Nat Med Panax notoginseng saponins prevent colitis-associated colorectal cancer via inhibition IDO1 mediated immune regulation. |